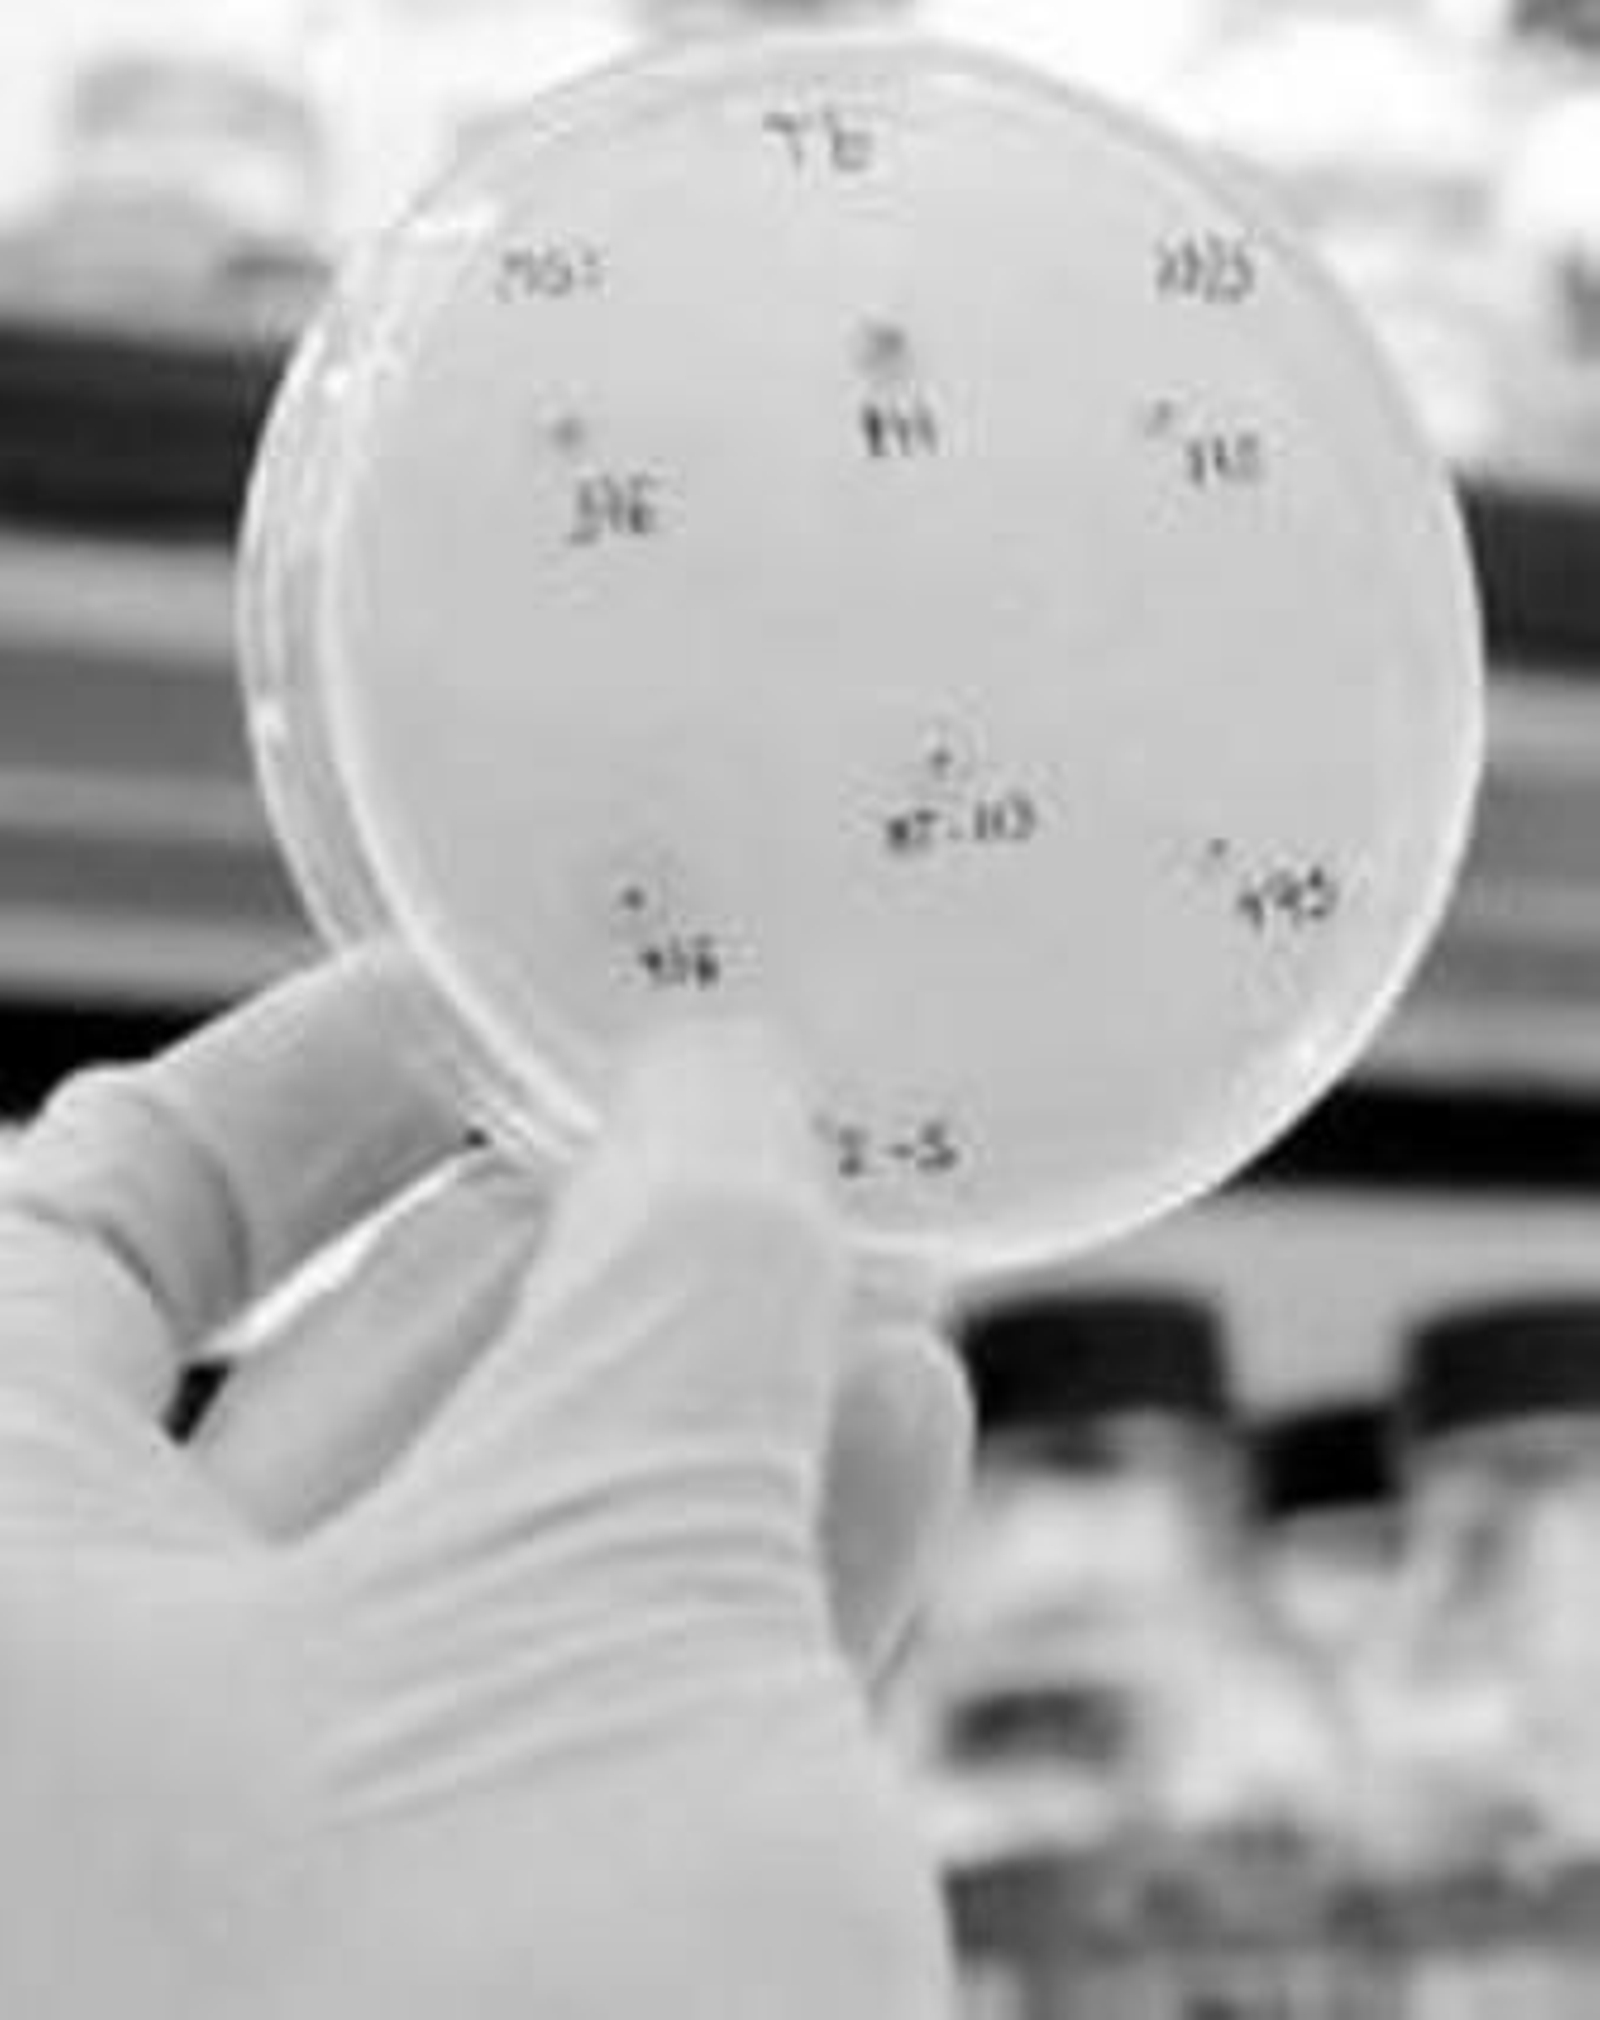

240 centros del país se suman a la prueba que adelanta el sexo del bebé
La red de trabajo ha permitido que Lorgen realice 118 análisis en el primer mes de funcionamiento del test · El resultado se conoce a las 48 horas y es muy fiable

Desde que hace un mes los laboratorios Lorgen pusieran en marcha su prueba para la identificación del sexo del bebé desde la sexta semana de gestación, el proyecto ha corrido como la pólvora y ya hay 240 centros colaboradores con el laboratorio granadino en todo el país. Así, una mamá de Pontevedra, o de cualquier parte de España, ya puede saber el sexo de su bebé a los dos meses de embarazo, en 48 horas y sin tener que trasladarse a Granada para realizarse las pruebas.
Esta posibilidad de adelantar el conocimiento del sexo del bebé con sólo un análisis de sangre de la madre no ha sido indiferente a nadie, y desde que se conoce el método Lorgen ha realizado 118 pruebas procedentes de toda España. Ha sido la disparidad de los destinos de los demandantes lo que ha hecho que las familias y la misma firma se ponga en contacto con centros de extracción y clínicas ginecológicas de los diferentes puntos para que sean referentes para proporcionar información y atender las demandas.
Desde Lorgen se muestran muy satisfechos en este primer mes de funcionamiento. "Es pronto para hacer balances exhaustivos, pero estamos muy satisfechos de la acogida del proyecto y del interés que ha despertado entre las parejas o madres de toda España", aseguró el gerente de Lorgen, Javier Valverde. Este primer mes, la mayoría de las demandas han sido de Madrid, Barcelona, Málaga y la Comunidad Valenciana.
El método del laboratorio granadino revolucionó el mundo de la Ginecología. Aunque no es una prueba nacida sólo para satisfacer la curiosidad de las futuras madres, sino que tiene un origen científico. De hecho, la verdadera utilidad es conocer el sexo del bebé lo antes posible en casos en los que exista la posibilidad de sufrir una enfermedad hereditaria o genética en la que el sexo es clave para desarrollarla o no, como la hemofilia.
En estos casos, en Andalucía se realiza la prueba en los hospitales y la cubre la Administración.
En la prueba se utiliza una muestra de sangre de la madre en la que se busca el ADN del niño. Y aunque se puede hacer a las seis semanas, la máxima fiabilidad llega a las ocho. Científicamente se conoce como RT-PCR, y ha supuesto un hito científico para el diagnóstico de patologías como la Distrofia Muscular de Duchenne y hasta 200 enfermedades más, casos en los que el SAS cubre económicamente la prueba. Por el contrario, si es una cuestión privada, el estudio cuesta 120 euros.
Para poner en marcha el proyecto, Lorgen colaboró con la Unidad de Medicina Fetal del Materno-Infantil. Probaron el sistema en más de 120 mujeres y se obtuvo un 98 por ciento de fiabilidad, tasa que se mantiene.
Hasta ahora, para conocer el sexo del bebé se realizan pruebas como la amniocentesis que, en algunos casos, puede causar problemas de aborto ya que se extrae una pequeña muestra del líquido amniótico que rodea al feto. Con todo, la prueba se realiza sólo en casos contados.
También te puede interesar
Lo último
Contenido ofrecido por Caja Rural Granada









